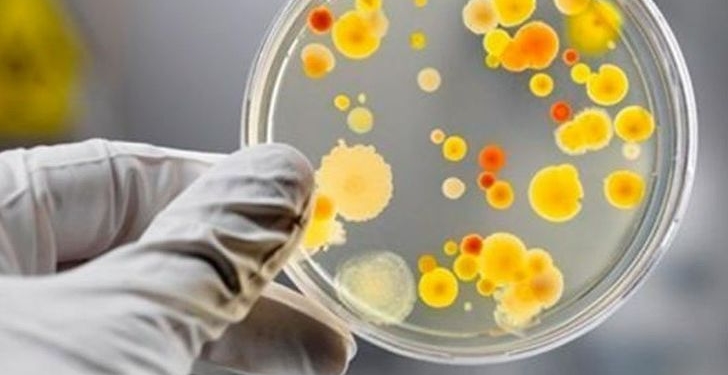
кишкова інфекція

“Потерпілі перебували на відпочинку в готелі “Карпатський затишок” у селищі Славське Стрийського району”, – йдеться в повідомленні.
Головна » 12 дітей госпіталізовані з кишковою інфекцією після відпочинку в готелі на Львівщині
12 дітей госпіталізовані з кишковою інфекцією після відпочинку в готелі на Львівщині
Коментарі
Нещодавні публікації
Рубрики публікацій
Теми
Свіжі новини
«Правий берег» (pb-news.info) – українське суспільно-політичне інтернет-видання, яке висвітлює актуальні події України та світу.
Медіа засноване у 2019 році.
«Правий берег» сповідує принципи оперативності, достовірності та аргументованості у поданні інформації.
Завдяки цьому публікації активно поширюються в соціальних мережах.
Усі права на інформаційні матеріали, розміщені на сайті «Правий берег» / pb-news.info, захищені українським законодавством про авторське право та інші суміжні права.
При використанні, передруку інформаційних та фото-,відеоматеріалів сайту, гіперпосилання на «Правий берег» має міститися в першому абзаці тексту.
Зв'яжіться з нами: tenews.te.ua@gmail.com